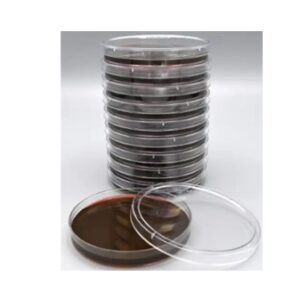
Método de Filtração em Membrana - Pesquisa de Coliformes Totais e Fecais

A linha de biorreatores líder da indústria da Sartorius possui recursos automatizados de hardware e software que permitem aos usuários desenvolver protocolos operacionais consistentes e confiáveis para todas as etapas.
Exibindo 1–12 de 135 resultadosClassificado por mais recente

A Bruker projeta e fabrica instrumentação analítica para análise elementar, pesquisa de materiais, investigações estruturais e de superfície.